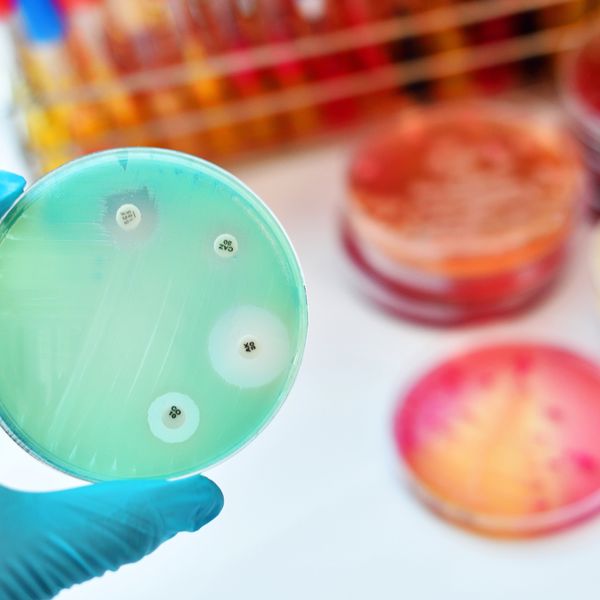
Monkeypox cases are on the rise: Are your workers protected?

Bird Flu and Monkey Pox: Keeping outbreaks out of the workplace
Worried about those newsworthy cases of bird flu or monkey pox making their way to your workplace? By exploring strategies that implement safety measures and recommended guidelines, you can help protect your workers and your bottom line.
Don’t let work go to the birds
Bird flu and monkey pox have been making an appearance across the country, forcing employers to take precautions to protect their workers from exposure and outbreaks. OSHA’s General Duty Clause requires employers to ensure a workplace free of recognized hazards, including pathogens like bird flu and monkey pox.
The Centers for Disease Control (CDC) reported that since April 2024, thirteen human cases of avian influenza (bird flu) have been reported in the United States. These types of outbreaks have medical professionals concerned due to the ease of infection across many animal species and countries.
The highest risk of infections occur when people work closely with cattle or chickens. Industries like poultry and food processing, veterinary services, and zookeeping are particularly susceptible to transmission.
Keep monkey business outside of work
According to the CDC, between 2022 and 2023, there were 32,063 cases of monkey pox (mpox) and 58 deaths. Monkey pox infections are spread through close personal contact with infected people, animals, or contaminated material. Medical evaluation is crucial to the proper diagnosis of this disease because it can be easily confused with other transmissible pathogens like chickenpox.
Most people with monkey pox recover in 2-4 weeks; however, it can be extremely serious especially to workers that may be immunocompromised, older, or pregnant. Additionally, healthcare and emergency response workers are especially susceptible to exposure.
Protect your workforce
As the CDC monitors and responds to these surging threats, employers should also implement a proactive illness prevention program that can ensure compliance with OSHA’s standards on Bloodborne Pathogens (1910.1030), Personal Protective Equipment (PPE) (1910.132), Respiratory Protection (1910.134), and other requirements related to specific organizational needs.
Protecting workers requires developing, implementing, and communicating specific procedures for worker interactions, personal hygiene, and sanitation of facilities. Worker safety may be as easy as remembering the three C’s:
- Communication – Encourage open communication with workers that may have exposure or have been previously exposed to any infectious disease can encourage early reporting and improve employee morale. Personal information should remain confidential as with any situation involving an employee’s medical information; however, general safety protocols can be put in place and communicated to the workforce to protect everyone. Cases should also be reported to public health officials to help identify exposure and prevent additional cases.
- Contact – Avoid close contact with infected individuals, objects, or materials that have potentially been exposed. Workers should also be wary of handling or sharing PPE, equipment, or other items handled by a person with an outbreak.
- Cleanliness - Practice effective personal hygiene and workplace sanitation. Hand hygiene, consisting of washing with soap and warm water for several seconds, is commonly recognized as the single most important practice to reduce the transmission of infectious agents. This is especially important prior to eating, touching your face, and after using the bathroom. In the absence of soap and water, approved alcohol-based products for hand disinfection are acceptable followed with washing as soon as soap and water is available. Additionally, workplace sanitation using EPA-approved disinfectants on work surfaces and doorknobs should be commonplace with contaminated materials and PPE being disposed of properly.
Keys to remember: Employers must be prepared to protect workers from bird flu and monkey pox with plans to encourage open communication, guide workers on close interaction and contact, and emphasize sanitation and personal hygiene methods.